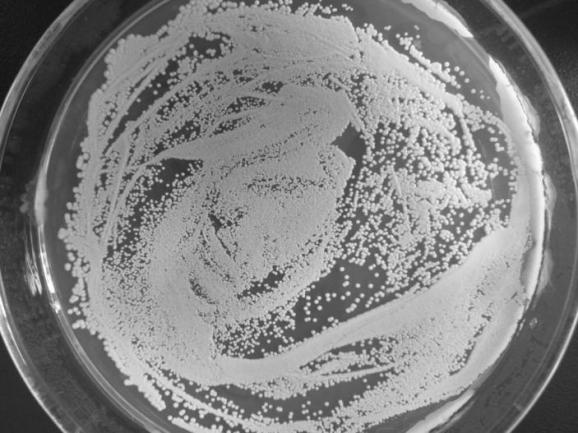

一株抗氧化酵母的筛选及鉴定毕业论文
2020-06-14 16:23:47
摘 要
酵母作为现代工业使用最广泛的生产菌,尤其是在生产酒精等方面。然而在工业生产过程中同时会出现多种不利菌体生长的因素,例如高温、高渗、低pH等环境,这些胁迫往往都会导致氧化胁迫,因此研究氧化胁迫同时可以为找到提高工业菌株的方法提供研究基础。
本课题采用传统育种手段,通过三级筛选的方法,从葡萄上筛选到一株具备一定抗氧化能力的酵母,通过ITS基因菌种鉴定系统鉴定后确定筛选得到的酵母菌株的种属是汉逊酵母,并命名为 Debaryomyces hansenii NCY-33。通过测定获得了30℃,180r/min以2%接种量在50ml YPD培养的生长曲线。NCY-33在YPD培养基内生长和新陈代谢速度快。NCY-33对DPPH的降解能力达到37%,脂质抗氧化能力达到67.15%。该酵母在含2mmol/L过氧化氢的YPD液体与固体培养基上皆能正常生长。10mmol/L 短暂处理后仍有大量菌体存活。
关键词: NCY-33;生长曲线 ;脂质抗氧化能力;基因序列分析法
Screening and Identification of an antioxidant yeast
ABSTRACT
Yeasts are used as the most widely used bacteria in modern industry, especially in the production of alcohol and so on. However, in the process of industrial production, there are many factors such as high temperature, high permeability, low pH and so on. These stresses often lead to oxidative stress. Therefore, the study of oxidative stress can be used to find the method of improving industrial strains Provide the basis for research.
In this study, a yeast with certain antioxidant ability was screened from the grapes by means of the three-stage screening method. After identification by the ITS gene identification system, the genotypes of the yeast strains were identified. Yeast, and named Debaryomyces hansenii NCY-33. The growth curve at 30 ° C and 180 r / min at 50% YPD was obtained by 2% inoculation. NCY-33 grows and metabolizes rapidly in YPD medium.NCY-33 degrades DPPH to 37%, and the antioxidant capacity of lipid reaches 67.15%. The yeast was normally grown on YPD liquid containing 2 mmol / L hydrogen peroxide and solid medium. 10mmol / L after a short treatment still a large number of bacteria to survive.
Key words:NCY-33;Growth curve;Lipid antioxidant capacity;Gene sequence analysis
目 录
摘 要 I
ABSTRACT II
第一章 前言 1
1.1 引言 1
1.2 自由基 1
1.3 自由基的作用 1
1.3.1 自由基的有益作用 1
1.3.2 自由基的有害作用 2
1.4 酵母抗氧化系统 2
1.4.1 氧化应激酶系统 2
1.4.2 非酶抗氧化体系 2
1.5 酵母菌鉴定方法 3
1.5.1 快速分类鉴定法 3
1.5.2 分子生物学鉴定技术 3
1.6 研究意义 3
1.7 研究背景 4
1.8 研究路线 4
第二章 材料与方法 1
2.1 材料 1
2.1.1 来源 1
2.1.2 培养基 1
2.1.3 主要仪器 1
2.1.4 主要试剂 2
2.2 实验方法 2
2.2.1 酵母菌的富集 2
2.2.2 一级筛选 3
2.2.3 二级筛选 3
2.2.4 三级筛选 3
2.2.5 斜面保藏 4
2.2.6 甘油冷冻保藏 4
2.2.7 测定生长曲线 4
2.2.8 菌种鉴定 4
2.2.9 生长曲线测定 6
2.2.10 过氧化氢耐受能力测定 6
第三章 结果 8
3.1 菌株的筛选 8
3.1.1 一级筛选 8
3.1.2 二级筛选 8
3.1.3 三级筛选 9
3.1.4 脂质抗氧化能力的测定 10
3.2 菌株的菌种鉴定 10
3.3 生长曲线测定 13
3.4 不同条件下过氧化氢耐受情况 14
3.4.1 不同浓度过氧化氢的YPD液体培养基生长情况 14
3.4.2 不同浓度的过氧化氢短时间应激 14
3.4.3 不同浓度过氧化氢YPD固体培养基生长情况 14
第四章 结论与展望 16
4.1 结论 16
4.2 展望 16
参考文献 17
致谢 19
第一章 前言
1.1 引言
酵母是单细胞兼性厌氧菌,在有氧环境与无氧环境均能生存 [1]。它具有培养方式简单、生长周期较短,可以使大量细胞同时处于某一状态且同步接受胁迫条件作用等特点。其细胞直径为(2.5-10)×(4.5-21)μm,形状包括球状、椭圆状、卵圆状、柱状以及香肠状等[2]。此外,研究酵母的科技日益发达,多种酵母的模式菌全基因组测序已经完成,这使今后的研究变得更加容易[3]。以上这些优质的特性决定了酵母菌是最理想的模式生物之一。因此,国际上生物学研究的热点就包括生命基本问题的基础性研究,其中研究是以酵母作为模式生物来开展的。另外酵母作为现代工业使用最广泛的生产菌,尤其是在生产酒精等方面。然而在工业生产过程中同时会出现多种不利菌体生长的因素,例如高温、高渗、低pH等环境,这些胁迫往往都会导致氧化胁迫,因此研究氧化胁迫同时可以为找到提高工业菌株的方法提供研究基础。
1.2 自由基
自由基又叫游离基(Free Radicals ),是指那些独立存在的含有不配对电子的原子或基团[4]。而不配对电子状态不稳定,易于其他化合物发生电子互换来达成稳定。自由基自身紊乱,通过迅速攻击电子来获得稳定,当被攻击的分子失去电子之后,它就变成了自由基,这就开始了一个恶性链锁循环反应。氧分子是呼吸作用或营养物质氧化的受体,在需氧生物氧化还原反应中至关重要。氧分子在被还原后,绝大多数生成水,然而还有一部分转化为了活性氧簇(ROS)。所以需要鉴别活性氧簇,从而判定氧化损伤程度。
1.3 自由基的作用
1.3.1 自由基的有益作用
生物体内会产生多种自由基,然后进行自我清理,达成平衡,从而对机体产生有益作用 [5]。人体内只有极少的自由基存在,它们通过产生电传导信号,刺激生物机体,来达到杀菌消炎的有益作用。最后分解清除有毒物质的。另外它们可以通过动脉来控制血液的流速、抵抗感染、使我们的大脑保持警戒和集中。有些低浓度的自由基与抗氧化剂类似,作为信号分子从而调控基因的表达;甚至某些自由基对癌细胞有抑制、杀灭以及清除作用;还有的自由基参与传导细胞信号[6-7]。
1.3.2 自由基的有害作用
羟自由基可以通过多种方式造成生物体氧化损伤。所以,羟自由基对生物体危害重大,增加癌症风险。羟自由基还与其他很多有害物质有关。超氧阴离子自由基可能会使DNA损伤,导致线粒体中的一些酶失去活性。这些酶与线粒体的功能是有关系的,尤其与NADH 脱氢酶中复合物Ⅰ的关系甚为密切。NADH 脱氢酶失活,线粒体的电子传递功链能就会受到损伤[4]。据科学证明,超氧阴离子自由基对人类具有有害作用。总体上ROS会对包括能量的产生,DNA、蛋白质和脂质在内的重要细胞组成成分造成氧化损害。除此之外,ROS还可能激活特异的信号通路。二者共同造成对酵母的氧化损伤。而在人体内,同样存在类似的情况。细胞结构被破坏,脂质过氧化都是因为拥有过多自由基造成的,从而使人体代谢活动紊乱。因此自由基对人类身体健康有着巨大威胁 [8]。比如阿尔兹海默病 [9],脑血栓以及肝脏炎症等疾病的产生,均发现由自由基的有害作用导致[10]。另外,氧自由基还与糖尿病[11]等代谢性疾病有关[12]。
1.4 酵母抗氧化系统
酵母细胞进化出防护自卫系统,用于抵御细胞自身氧化损伤,该系统分为以下两类。
1.4.1 氧化应激酶系统
氧化应激酶系统包括超氧化物歧化酶(SOD)、过氧化氢酶(CAT)等几种过氧化物酶以及谷胱甘肽过氧化物酶(GSH-PX)。SOD是机体内超氧阴离子唯一的天然酶类清除剂,可将超氧阴离子转化为H2O2,随后CAT与GSH-PX可以将H2O2进一步降解。CAT是一种血红素酶,能够将H2O2分解生成H2O与O2。,氧化应激酶系统在清除胞内ROS的过程中至关重要。
1.4.2 非酶抗氧化体系
非酶抗氧化体系含有一些维生素和其他营养素。其中谷胱甘肽是由谷氨酸、半胱氨酸和甘氨酸结合而成的三肽[8]。因其含有一个游离的活性巯基,所以具有抗氧化能力,能抵抗氧化剂。硫氧还蛋白系统由硫氧还蛋白(Trx),硫氧还蛋白还原酶(TrxR)和还原型烟酰胺腺嘌呤二核苷磷酸(NADPH)组成[9]。硫氧还蛋白是由两个半胱氨酸组成的蛋白质,硫氧还蛋白的活性中心可以与底物蛋白相结合,结合出硫基,同时硫氧还蛋白被氧化,而氧化状态的硫氧还蛋白又可以在硫氧还蛋白还原酶和还原型烟酰胺腺嘌呤二核苷磷酸的作用下被还原,从而构成硫氧还蛋白氧化还原的循环系统,用以清除胞内的氧化活性物质[14]。
1.5 酵母菌鉴定方法
酵母菌的分类鉴定的方法中最常见的为传统分类法。其中传统分类法又可分为以下几种:(1)根据菌落形态分类对酵母菌进行鉴定,比如颜色、隆起、透明度、边缘、光泽或者菌体形态;(2)根据生理生化性状分类对酵母菌进行鉴定,比如耐酸、尿素分解、耐糖、同化碳源、产酸、产酯、发酵糖类、同化氮源、产生类淀粉化合物、石蕊牛奶、分解脂肪、明胶液化、无纤维素培养基上的生长等[15]。
1.5.1 快速分类鉴定法
根据《酵母菌的特征与鉴定手册》等鉴定手册,对酵母菌的特征进行逐一比对获得结果[16]。然而由于传统方法工作量大、步骤繁琐,需要耗费大量的时间和精力,因此近年来针对酵母菌的现代性的快速分类鉴定法应运而生。
1.5.2 分子生物学鉴定技术
分子生物学鉴定技术种类较多,主要方法有基因序列分析法、PCR-RAPD技术、AFLP技术等。其中基因序列分析法得益于现在的DNA序列分析技术越发成熟先进,一般是通过观察rDNA及其转录区间ITS的序列,包括D1/D2区位、ITS1、ITS2区位以及18SrDNA区域,进而判定酵母菌类型。D1/D2区变异率较髙,可用于酵母的分类。对此,前人已有详实的研究,结果表明大部分酵母菌种利用D1/D2区序列来进行鉴定,且该方法快速有效,但是该方法不适合用于发现新品种菌种[8-11]。ITS区包括ITS1和ITS2,其中也包括5.8S区。研究表明即便是两个种类亲缘关系非常接近,依然可以在ITS序列上显示最近的进化特征[17]。此外,18SrDNA区域也含有变异率较髙的区段,可用于酵母菌的分类鉴定,因此本论文将采用ITS基因序列,对菌种进行鉴定。
1.6 研究意义
酵母在野生环境或工业生产发酵过程中往往会遇到一些极端的生存条件:如高温,低pH,渗透压,辐射等。极端条件下细胞内ROS的产生速度与抗氧化防御系统的清除速度相差变大,动态平衡被打破,从而细胞内的ROS大量聚集导致机体氧化损伤。而这种动态平衡与人类身体健康有着紧密的关系[18]。因此,近年对自由基抗氧化的研究已成为生物化学和医药中的重点。
1.7 研究背景
随着人类生命科学迅速发展,科学技术日新月异,氧化和抗氧化研究成为前沿和热点课题。如何挑选和鉴定具有抗氧化活性的大自然物产,是生物化学和医药研究的又一新兴焦点。关于乳酸菌饮料的研究不论在国内还是国外都有了一定的成果和进步。但酵母菌的抗氧化研究目前国内外还较少。因此本实验以过2mmol/l过氧化氢,1,1-二苯基-2-三硝基苯肼,别名:二苯基苦基苯肼自由基(DPPH·)降解能力以及脂质抗氧化能力为筛选指标,从自然界中获取具有一定抗氧化能力的酵母菌,为此后的抗氧化机制的分子研究奠定基础[19]。
1.8 研究路线
使用完全培养基初步富集活化样品中的酵母,使用含有2mM的H2O2的YPD固体平板进行一级筛选。使用TTC培养基进行二级筛选,通过测定DPPH·降解能力进行三级筛选,从而获得具有抗氧化能力的目的酵母。随后对该菌的基础参数进行测定包括:正常条件下NCY-33的生长曲线,以及不同培养条件下过氧化氢耐受能力。
第二章 材料与方法
2.1 材料
2.1.1 来源
从市场上购买的不同产地的葡萄。
2.1.2 培养基
富集培养基:10g/L蛋白胨、1g/L K2HPO4、5g/L Na2CO3、0.1g/L MgSO4·7H2O、0.015g/L FeSO4·7H2O、0.05g/L MnSO4、10g/L酵母膏,pH 6.0。
富集培养基:麦芽汁培养基
相关图片展示: